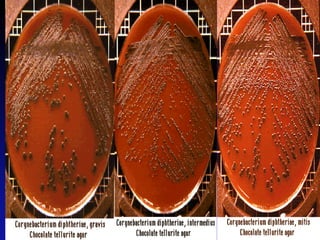
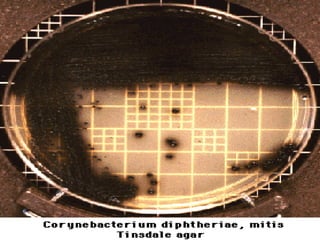

1) In 1884, Loeffler identified Corynebacterium diphtheriae as the bacterial agent that causes diphtheria and described its toxin-producing ability.
2) Diphtheria is an infection of the throat caused by C. diphtheriae that forms a pseudomembrane and releases exotoxins which can damage organs.
3) Diphtheria was largely controlled through vaccination programs using formaldehyde-inactivated toxoid, though remains endemic in some areas due to poverty and social factors.